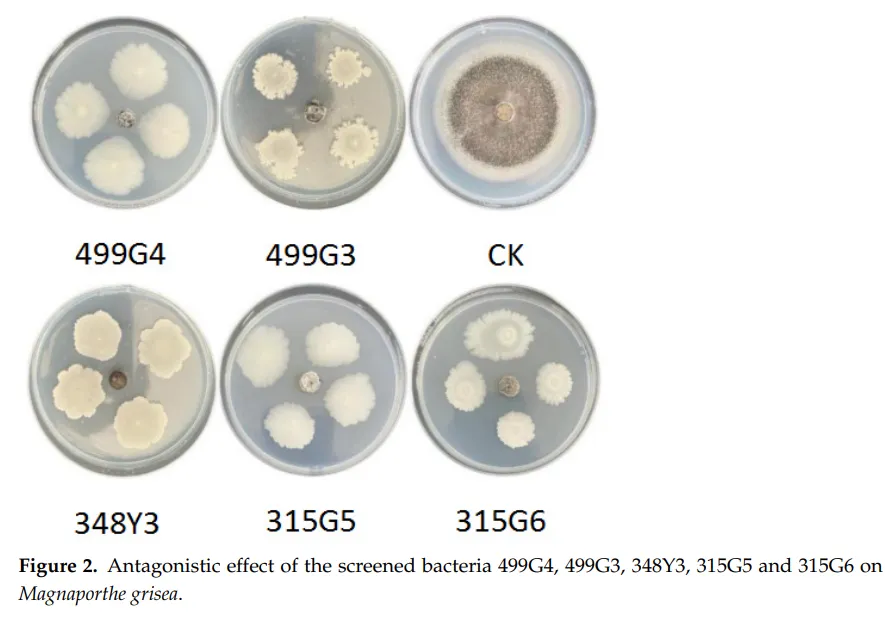

解读人:普苑明(云南农业大学烟草学院2025级研究生,导师杨金广)
稻瘟病是由稻瘟病菌(Magnaporthe grisea)引起的重要水稻病害,因全球分布广、致产量损失严重,成为水稻种植中最关键的病害之一。其可导致水稻叶片和穗部坏死,其中穗瘟危害远超叶瘟,会造成更大幅度减产。野生稻蕴藏丰富的抗稻瘟病资源,其抗病、抗虫基因常被用于栽培稻育种。大量研究证实,内生菌、丛枝菌根真菌(AMFs)、根瘤菌等微生物在寄主植物进化中发挥重要作用,通过与寄主的紧密互作提升植物抗逆性,这一特性在野生物种中尤为显著。
2022年7月,中国科学院东北地理与农业生态研究所姚宗木团队在国际学术期刊《Microorganisms》发表题为“Culturable Screening of Plant Growth-Promoting and Biocontrol Bacteria in the Rhizosphere and Phyllosphere of Wild Rice”的研究论文。该研究从4个野生稻品种的根际和叶际筛选出45株形态不同的细菌,功能验证显示:18株对稻瘟病菌具有显著拮抗活性,33株具备溶磷、溶钾或固氮能力。盆栽试验证实,3株菌株——499G2(简单类芽孢杆菌,Peribacillus simplex)、499G3(贝莱斯芽孢杆菌,Bacillus velezensis)、499G4(巨大芽孢杆菌,Bacillus megaterium),不仅能抗稻瘟病,还能显著促进栽培稻生长,提升植株叶片总氮、总磷、总钾、吲哚乙酸(IAA)及叶绿素含量;在稻瘟病侵染验证中,施用这 3 株菌的接种剂可显著降低丙二醛(MDA)含量、提高可溶性糖含量及植物抗氧化酶活性,进而增强水稻对稻瘟病的抗性。

经NBRIP培养基(溶磷筛选)、钾溶液培养基(溶钾筛选)等选择性培养基鉴定,29株细菌具备溶磷、溶钾或固氮能力(表3),其中3株菌株(218G1、218G4、348G1)可同时实现固氮、溶磷、溶钾,5株菌株(348Y7、315Y7、315G5、218Y3、348Y5)兼具溶磷和溶钾能力,218G7具有固氮和溶钾功能,315Y2 具有固氮和溶磷功能。促生能力按菌落生长和透明圈大小分级:能在选择性培养基生长(+)、透明圈与菌落等大(++)、透明圈略大于菌落(+++)、透明圈超菌落2倍(++++),其中499G5和315Y5的溶钾能力最突出,但对磷酸三钙的溶出效果较弱。

对18株拮抗菌株进行盆栽促生实验,11株表现出促生作用,其中499G2、499G3、499G4的效果最显著。施用接种剂后,水稻叶片宽度、根长、茎长、鲜重均有显著提升(图3)。具体来看,叶片宽度方面,499G2、499G3、499G4 处理组分别比对照增加7.97%、9.78%、9.06%;根长方面,499G2处理组增加13.17%,499G3、499G4对根长影响不显著;茎长方面,499G3处理组增加39.61%,499G2、499G4 分别增加18.51%、25.16%;鲜重方面,499G3处理组增加125.79%,与该菌株显著促进地上部生长相关。营养与生理指标方面,499G4能有效提高植株总氮水平,比对照提高33.33%;499G2、499G3、499G4分别使叶片磷含量提高10.44%、17.01%、5.45%;仅499G3显著提高叶片钾含量(8.17%)(图4)。IAA积累量和叶绿素含量上,施用499G2和499G3后,水稻植株IAA含量分别比对照增加4.90%、6.82%;施用 499G4后IAA降低,但能显著提高叶绿素a、叶绿素b及总叶绿素含量,其中叶绿素b增幅达56.92%,499G3对叶绿素的提升幅度分别为13.60%、31.92%、20.24%,499G2 对光合作用无显著影响(图5)。



通过测定稻瘟病侵染后水稻叶片的MDA、脯氨酸(Pro)、可溶性糖(SS)、超氧化物歧化酶(SOD)、过氧化物酶(POD)含量,揭示了菌株的抗病机制。稻瘟病侵染后对照组长高126.67%,499G2、499G3、499G4处理组分别比“仅接稻瘟病”对照组降低16.31%、21.39%、11.76%,减轻细胞膜脂质过氧化损伤;各处理组脯氨酸含量均显著升高,499G3+PoC(稻瘟病)处理组增幅最大(33.43%),增强植株渗透压调节能力;随稻瘟病侵染,各组可溶性糖含量均显著升高,499G3+PoC处理组增幅达13.51%,499G2+PoC增幅为12.56%,为细胞提供能量并维持膜完整性;稻瘟病侵染10天后,SOD活性提升12.92%-15.73%,POD活性提升14.69%-20.66%,显著增强植株清除活性氧(ROS)的能力(图6)。

综上所述,该研究从4个野生稻品种的根际和叶际筛选出45株细菌,其中 18株抗稻瘟病、29株具备溶磷/溶钾/固氮能力。499G2、499G3、499G4三株菌株不仅能通过直接拮抗抑制稻瘟病,还能通过提升水稻营养水平、调节生理代谢(IAA、叶绿素)、增强抗氧化防御系统,实现促生及抗病双重功效。这些菌株为绿色生物菌剂的研发提供了优质菌种资源,在农业可持续发展中具有广阔应用前景。
END

➤【学术之光】山西大学张犇教授以共同指导作者在Nature plants发表研究论文解析植物GORK钾通道门控调控机制
➤【学术之光】河南农业大学科技团队绿色防控助力粮食安全,积极推进创新成果转化
廖新阳(四川农业大学农学院)
国志信(河南农业大学园艺学院)
郭建伟(昆明学院云南省魔芋生物学重点实验室)
郝宇琼(山西农业大学)
黄俊文(肇庆学院生命科学学院)
蒋伟(湘湖实验室/南京农业大学)
李正男(内蒙古农业大学园艺与植物保护学院)
李博(湖北省农业科学院粮食作物研究所)
廖新阳(四川农业大学农学院)
吕斌娜(中国农业科学院烟草研究所)
聂文锋(山东农业大学园艺科学与工程学院)
舒灿伟(华南农业大学植物保护学院)
夏子豪(沈阳农业大学植物保护学院)
徐晓召(青岛农业大学园艺学院)
赵旭升(中国科学院深圳先进技术研究院)
朱玉涛(河南城建学院生命科学与工程学院)